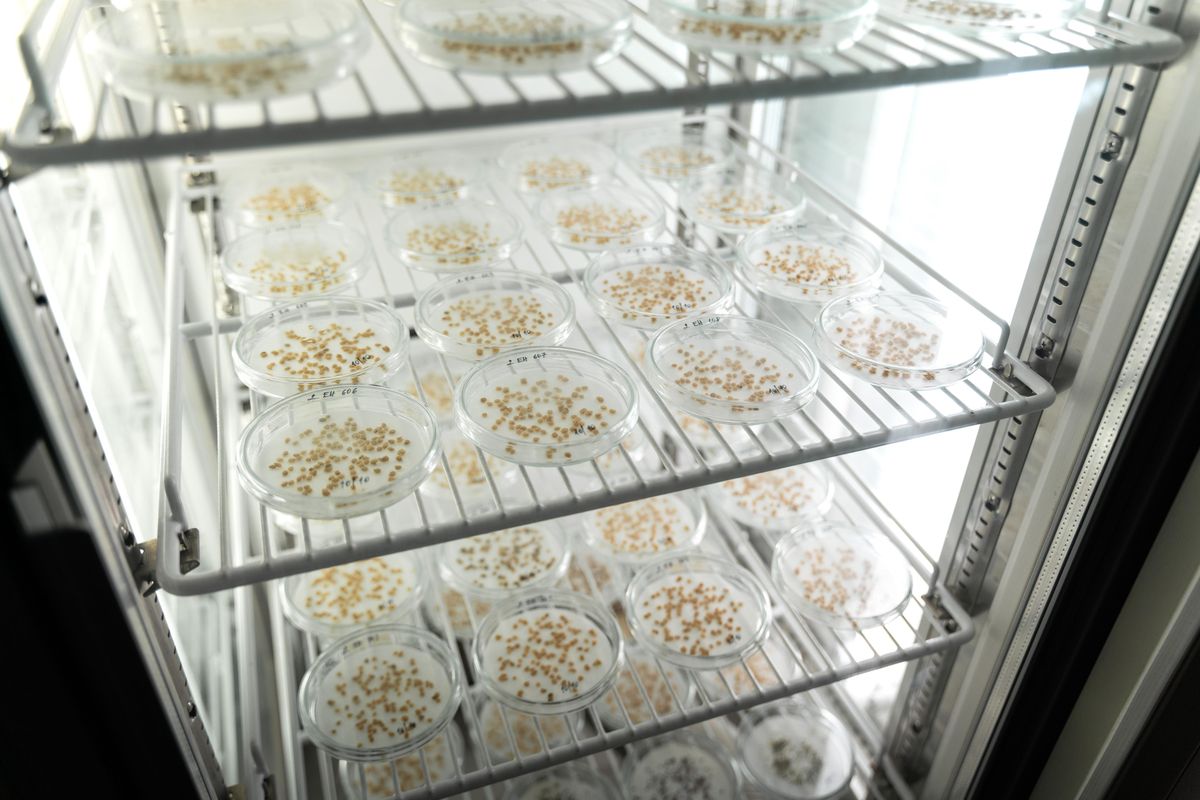

Článek
Pracovnice skladu genové banky Anna Prohasková sype v prosvětlené místnosti vysušená semínka z papírového sáčku na petriho misku. Zkoumá, zda jsou v pořádku. „Musím zkontrolovat, jestli jsou semínka správně označená,“ vysvětluje.
Potom etiketu s informacemi o semenech nalepí na stříbrný aluminiový pytlík. Do něj následně obsah misky nasype a přidá k němu sáček s oranžovým silikagelem, který pohltí přebytečnou vlhkost. Nahřátými kleštěmi pytlík zapečetí a vloží ho do červené plastové krabice k ostatním vzorkům. Plnou krabici čeká cesta na samou severní výspu Evropy - souostroví Špicberky, kde se připojí k dalším semenům v Globálním úložišti semen.
„Potřebujeme co nejširší spektrum materiálů, které mají co nejširší vlastnosti, abychom měli z čeho vybírat,“ říká vedoucí genové banky Dagmar Janovská. Do úložiště poputují například semínka mrkve, salátu, pšenice nebo máku. Semena byla vybrána podle důležitosti pro výživu a zemědělství.

Anna Prohasková zapečeťuje sáček se semeny pomocí nahřátých kleští.
Archa Noemova k uchování genového bohatství rostlin
V úložišti na Špicberkách je schraňováno při teplotě -18 stupňů přes 1,3 milionu vzorků rostlinných semen z celé planety. Maximálně by mohla pojmout až 4,5 milionu vzorků. Úložiště není přístupné, dovnitř se dostanou pouze pracovníci NordGen (Nordic Genetic Resource Center, severská genová banka), kteří tam ukládají vzorky, a to pouze v předem ohlášené dny třikrát ročně.
Globální úložiště semen slouží k dlouhodobému skladování semen z genových bank mnoha zemí. Je součástí mezinárodního systému pro zachování genetické rozmanitosti rostlin, který řídí organizace OSN pro výživu a zemědělství.
„V případě, že bychom měli tady problém se semeny, tak na Špicberkách máme bezpečnostní duplikaci a můžeme si je vyžádat zpět a začít znova pěstovat,“ popsala vedoucí skladu a dokumentace české genové banky Ludmila Papoušková. Pokud by semena rostlin kvůli politickým konfliktům, přírodním katastrofám nebo jakémukoliv jinému důvodu byla zničena jak v genové bance, tak i všude jinde v Česku, na Špicberkách je záloha. „Už je to deset let od první zásilky a zatím nebyl důvod, abychom si je vyžádali zpátky,“ řekla Papoušková.
Zatím si svá semínka vyžádala pouze jedna genová banka, International Center for Agricultural Research in the Dry Areas. Zásoba semen v Sýrii byla zničena v důsledku občanské války. „Díky bezpečnostním duplikátům semen na Špicberkách byla ICARDA schopna založit nová úložiště semen v Maroku a Libanonu,“ uvedl koordinátor globálního úložiště Åsmund Asdal.

Globální úložiště semen na Špicberkách.
Na rozdíl od semen v genové bance, která se používají pro výzkum i vzdělávání, vzorky na Špicberkách jsou v zapečetěných sáčcích a nikdo je nevyndává ven. Jsou stále majetkem České republiky a nikdo jiný je vyžádat nemůže. „Momentálně máme na Špicberkách 1900 vzorků semen, teď posíláme dalších 150. Vybrali jsme ta nejvzácnější semena českého původu, která potřebujeme pro šlechtění. Posíláme tam olejniny, zeleninu, pšenici, ječmen a další vzorky,“ vysvětlila Papoušková.
Před uložením vzorků Česko uzavírá dohodu s norskou vládou, která trvá 10 let. Po uplynutí doby je možné ji prodloužit. Úložiště funguje už 16 let, Česká republika do něj poslala vzorky semen v letech 2015, 2018, 2020, 2021 a 2023. Letošní zásilky na Špicberky musí dorazit do pátku 17. října.
Vysušit, zchladit, vyklíčit
Česká genová banka v pražské Ruzyni ve svých prostorách uchovává přes 43 tisíc položek, které jsou uskladněny ve více jak 100 tisících sklenic. Před uskladněním se semínka nejdřív musí usušit.
„To trvá několik dní až týdnů, záleží na odrůdě,“ vysvětluje Anna Prohasková, zatímco ukazuje misky se semeny naskládané ve stísněné sušárně. Podél zdí jsou držáky na misky a je potřeba zavírat dveře, aby se dovnitř zbytečně nedostávala vlhkost zvenčí. „Vlhkost je potřeba dostat na pět procent,“ upozorňuje Prohasková. Semínka se totiž uchovávají při zmíněné teplotě -18 stupňů a voda by v nich zmrzla, narušila jejich strukturu a zničila by je.
Po vysušení se semena přesunou do chladové komory. Těch se v genové bance nachází deset a jsou to velké místnosti obložené až do stropu regály se zelenými plastovými krabicemi, ve kterých jsou naskládané sklenice plné semen. Nízká teplota jim zajišťuje dlouhou životnost. „Záleží na druhu, semena pšenice například v těchto podmínkách vydrží až 30 let,“ líčí Papoušková, která si musí vzít do chladové komory tlustou zimní bundu.

Ludmila Papoušková v chladové komoře.
Kvalitu semínek přezkoumává výzkumný tým genové banky po deseti letech. Vzorek semen pracovníci vysypou na petriho misku a vloží do inkubátoru, který se vzhledově velmi podobá lednici. Tam pak kontrolují klíčivost. Hodnoty poté zaznamenají. Úspěšná klíčivost je u každé plodiny definována trochu jinak, platí ale, že pokud vyklíčí méně než 50 procent, je to problém. „V takovém případě kontaktujeme všechny kurátory,“ říká vedoucí instituce Dagmar Janovská.
Genová banka uchovává rostlinná semena, zkoumá je a šlechtí. Zdarma poskytuje vzorky semen, o které si lidé žádají poměrně běžně. „Šlechtěním se snažíme vyvinout nejen odolnější odrůdy, ale i s větší nutriční hodnotou,“ dodává Janovská.
Inkubátor, kde se zkoumá klíčivost semen.